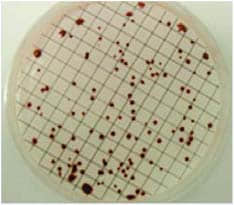

服务热线
18017322602
15900658720
简要描述:
混合纤维素膜(CA-NC膜,或ME膜)
Whatman混合纤维素酯膜由硝酸纤维素(NC)和醋酸纤维素(CA)混合制成,它比纯硝酸纤维素膜具有更好的平整性和均匀性,为检测颗粒物和微生物提供了更好的颜色对比,减少了眼睛疲劳。ME型混合纤维滤膜比WME型混合纤维素膜具有更低的醋酸纤维素含量,生物相容性更佳。
简化计数过程
在微生物菌落计数过程中,表面同菌落的颜色反差会使得计数过程更加简便。
光滑或网格
许多微生物检测法以培养后的菌落计数作为定量标准。 Whatman网格滤膜内有间隔3.1 mm或者5 mm的网格线。用特殊的无毒性的墨水,并且完全不含细菌生长的抑制剂。
无菌膜
Whatman提供已包装好的无菌滤膜来提高操作效率,节省了大量时间,且无菌滤膜自带黑色或白色网格,方便菌落计数。
特征和优点
·已消毒了的膜可供主要实验选择
·非常好的对比,方便颗粒检测
·网格没有毒性,也不会抑制细菌生长,保证样品的完整性
·黑色平滑或者黑色网格膜中混合了硝酸纤维素和醋酸纤维素
·膜提供了高的内表面积,适合吸附力更高的产品
·更高的灰尘负载力
·生物学惰性,良好的热稳定性
·不含表面活性剂,不会污染样品
·膜均匀的微孔结构提高了流速
·热稳定性
Whatman黑色混酯膜中光滑型用于自动克隆计数,而网格型则用于人工计数。黑膜使的残留物或者细胞颜色和膜之间颜色有差异,从而不必对膜进行染色处理。
应用
Whatman混合纤维素膜在要求更高流速和更大过滤容量的应用中非常有效,包括了水溶液的澄清或消毒、分析和去除颗粒、空气监测和微生物分析,其他应用包括:
·水溶液的澄清或冷灭菌
·细胞学
·空气监测
·HPLC 样品制备(水相)
·病毒浓缩
·颗粒物分析
·生物检测
·食品微生物包括E.coli计数
·细菌生物学研究
·液体颗粒物计数或气溶胶观察
·酵母和霉菌
| 技术参数-混合纤维素酯膜 | |
| 普通 | |
| 爆裂强度 | > 10 psi |
| 重量 | 4.3-5.0 mg/cm2 |
| 最高操作温度 | 130°C |
| 孔率 | 74-77% |
| 蒸汽高压灭菌 | 是 |
| 抗溶剂 | 中等 |
| 蛋白吸附力 | 中等 |
产品选择-混合纤维素酯膜 | ||||||
| 膜型号 | 孔径(μm) | 厚度(μm) | 水流速 | 空气流速 Δp = 3 mbar (bar) (s/100 ml) | 起泡点(psi) | 起泡点(bar) |
| WME混合纤维素酯膜 | - | 140 | – | – | – | – |
| ME混合纤维素酯膜 | ||||||
| ME 24 | 0.2 | 135 | 20 | – | 53.65 | 3.7 |
| ME 25 | 0.45 | 145 | 12.5 | – | 40.6 | 2.8 |
| ME 26 | 0.6 | 135 | 48 | 21 | 27.55 | 1.9 |
| ME 27 | 0.8 | 140 | 2.8 | 11.6 | 18.85 | 1.3 |
| ME 28 | 1.2 | 140 | 2 | 9.3 | 11.6 | 0.8 |
| ME 29 | 3 | 150 | 1.2 | 6.7 | 10.15 | 0.7 |
| 订货信息-混合纤维素酯膜(大张卷膜) | ||||
| 目录 | 孔径(μm) | 颜色 | 描述 | 数量/包 |
| 10401605 | 0.45 | 白色 | ME25 0.45um 300mm×100m (宽*长) | 1 |
| 10409702 | 0.45 | 黑色 | ME25/3 0.45um 300mmx100m(宽*长) | 1 |
订货信息-混合纤维素酯膜 | ||||
尺寸(mm) | 孔径 (μm) | 目录号 | 描述 | 数量/包 |
ME系列-ME24, 平坦无网格 | ||||
25 | 0.2 | 10401706 | 平滑 | 100 |
47 | 0.2 | 10401712 | 平滑 | 100 |
47 | 0.2 | 10401770 | 平滑,(已灭菌,无菌包装) | 100 |
50 | 0.2 | 10401714 | 平滑 | 100 |
50 | 0.2 | 10401772 | 平滑, (已灭菌,无菌包装) | 100 |
100 | 0.2 | 10401721 | 平滑 | 50 |
110 | 0.2 | 10401726 | 平滑 | 50 |
142 | 0.2 | 10401731 | 平滑 | 25 |
ME系列-ME25, 平坦无网格 | ||||
25 | 0.45 | 10401606 | 平滑 | 100 |
47 | 0.45 | 10401612 | 平滑 | 100 |
47 | 0.45 | 10401670 | 平滑,(已灭菌,无菌包装) | 100 |
50 | 0.45 | 10401614 | 平滑 | 100 |
50 | 0.45 | 10401662 | 无衬纸 | 100 |
50 | 0.45 | 10401672 | 平滑,(已灭菌,无菌包装) | 100 |
90 | 0.45 | 10401618 | 平滑 | 50 |
100 | 0.45 | 10401621 | 平滑 | 50 |
110 | 0.45 | 10401626 | 平滑 | 50 |
142 | 0.45 | 10401631 | 平滑 | 25 |
ME系列-ME26, 平坦无网格 | ||||
25 | 0.6 | 10401506 | 平滑 | 100 |
47 | 0.6 | 10401512 | 平滑 | 100 |
50 | 0.6 | 10401514 | 平滑 | 100 |
ME系列-ME27, 平坦无网格 | ||||
25 | 0.8 | 10400906 | 平滑 | 100 |
37 | 0.8 | 10400909 | 平滑 | 100 |
47 | 0.8 | 10400912 | 平滑 | 100 |
50 | 0.8 | 10400914 | 平滑 | 100 |
100 | 0.8 | 10400921 | 平滑 | 50 |
ME系列-ME28, 平坦无网格 | ||||
25 | 1.2 | 10400806 | 平滑 | 100 |
47 | 1.2 | 10400812 | 平滑 | 100 |
50 | 1.2 | 10400814 | 平滑 | 100 |
100 | 1.2 | 10400821 | 平滑 | 50 |
*产品仅适用于美国
订货信息-混合纤维素酯膜 | ||||
尺寸(mm) | 孔径 (μm) | 目录号 | 描述 | 数量/包 |
ME系列-ME29, 带网格 | ||||
25 | 3 | 10400706 | 平滑 | 100 |
47 | 3 | 10400712 | 平滑 | 100 |
50 | 3 | 10400714 | 平滑 | 100 |
50 | 3 | 10400772 | 平滑, (已灭菌,无菌包装) | 100 |
ME系列-ME24, 带网格 | ||||
47 | 0.2 | 10406970 | 白色/黑色网格3.1 mm,无菌 | 100 |
50 | 0.2 | 10406972 | 白色/黑色网格3.1 mm,无菌 | 100 |
ME系列-ME25, 带网格 | ||||
47 | 0.45 | 10406812 | 白色/黑色网格3.1 mm | 100 |
47 | 0.45 | 10407970 | 白色/黑色网格3.1 mm, 无菌 | 100 |
47 | 0.45 | 10406871 | 白色/黑色网格3.1 mm, 无菌 | 1000 |
47 | 0.45 | 10406512 | 白色/黑色网格5 mm | 100 |
47 | 0.45 | 10409770 | 黑色/白色网格3.1 mm,无菌 | 100 |
47 | 0.45 | 10409771 | 黑色/白色网格3.1 mm, 无菌 | 1000 |
47 | 0.45 | 10409414 | 绿色/黑色网格 3.1 mm | 1000 |
50 | 0.45 | 10406814 | 白色/黑色网格3.1 mm | 100 |
50 | 0.45 | 10406862 | 白色/黑色网格3.1 mm, 无衬纸 | 100 |
50 | 0.45 | 10406514 | 白色/黑色网格5 mm | 100 |
50 | 0.45 | 10406572 | 白色/黑色网格5 mm, 无菌 | 100 |
50 | 0.45 | 10406562 | 白色/黑色网格5 mm, 无衬纸 | 100 |
50 | 0.45 | 10409714 | 白色/黑色网格3.1 mm | 100 |
50 | 0.45 | 10409772 | 白色/黑色网格3.1 mm, 无菌 | 100 |
50 | 0.45 | 10409462 | 绿色/黑色网格3.1 mm, 无衬纸 | 100 |
47 | 0.45 | 10406800 | 精品膜系列,白色/黑网格3.1mm 无菌 | 100 |
50 | 0.45 | 10406801 | 精品膜系列,白色/黑网格3.1mm 无菌 | 100 |
50 | 0.45 | 10406802 | 精品膜系列,白色/黑网格3.1mm 无菌 | 400 |
47 | 0.45 | 10406803 | 精品膜系列,白色/黑网格3.1mm 无菌 | 400 |
ME系列-ME26, 带网格 | ||||
50 | 0.6 | 10409814 | 黑色/白色网格grid 3.1 mm | 100 |
ME系列-ME27, 带网格 | ||||
47 | 0.8 | 10408970 | 白色/黑色网格3.1 mm, 无菌 | 100 |
47 | 0.8 | 10409970 | 白色/黑色网格3.1 mm with pad, 无菌 | 100 |
47 | 0.8 | 10409270 | 黑色/白色网格3.1 mm, 无菌 | 100 |
50 | 0.8 | 10405672 | 绿色/黑色/网格3.1 mm, 无菌 | 100 |
ME系列-ME28,带网格 | ||||
50 | 1.2 | 10408472 | 绿色/黑色/网格3.1 mm, 无菌 | 100 |
WME系列-带网格 | ||||
25 | 0.45 | 7141-002 | 白色/黑色网格3.1 mm | 100 |
25 | 0.8 | 7148-002 | 白色/黑色网格3.1 mm | 100 |
47 | 0.45 | 7140-104 | 平滑, 无菌 | 100 |
47 | 0.2 | 7187-114 | 白色/黑色网格3.1 mm | 100 |
47 | 0.45 | 7141-004 | 白色/黑色网格3.1 mm | 100 |
47 | 0.45 | 7141-104 | 白色/黑色网格3.1 mm, 无菌 | 100 |
47 | 0.45 | 7141-114 | 白色/黑色网格3.1 mm, 无菌,无垫片 | 100 |
47 | 0.45 | 7141-124 | 白色/黑色网格3.1 mm, 无菌 | 200 |
47 | 0.45 | 7141-154 | 白色/黑色网格3.1 mm, 无菌, 无垫片 | 1000 |
47 | 0.45 | 7141-204 | 白色/黑色网格3.1 mm, 高压无菌包, 无菌 | 100 |
47 | 0.45 | 7153-104 | 黑色/白色网格3.1 mm, 无菌 | 100 |
*产品仅适用于美国
